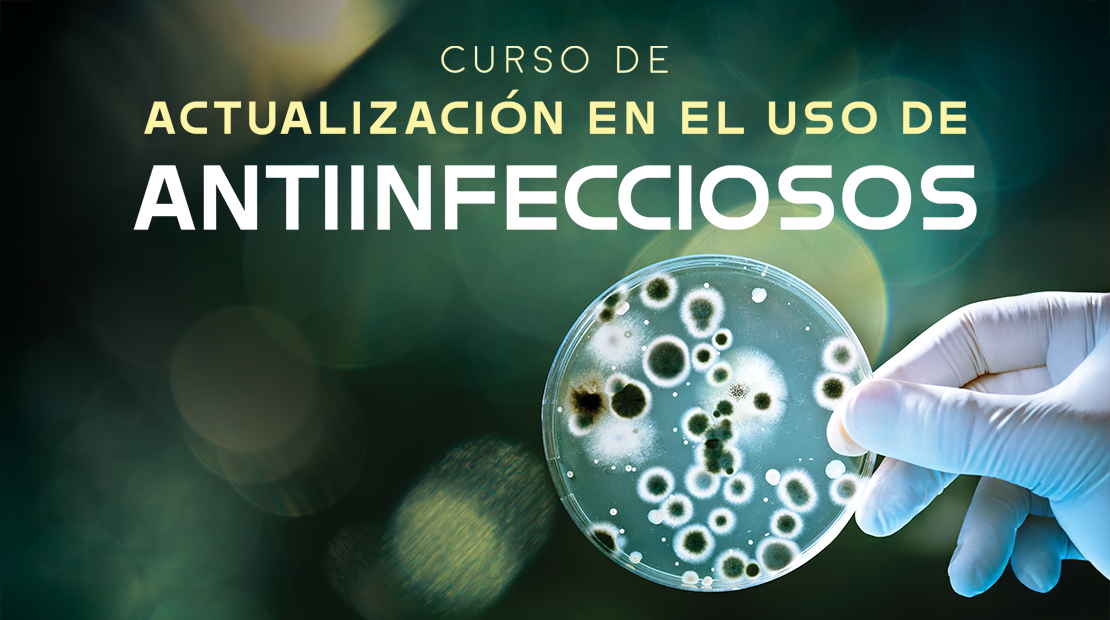

Actividades Académicas de disponibilidad programada













Actividades Académicas de disponibilidad total